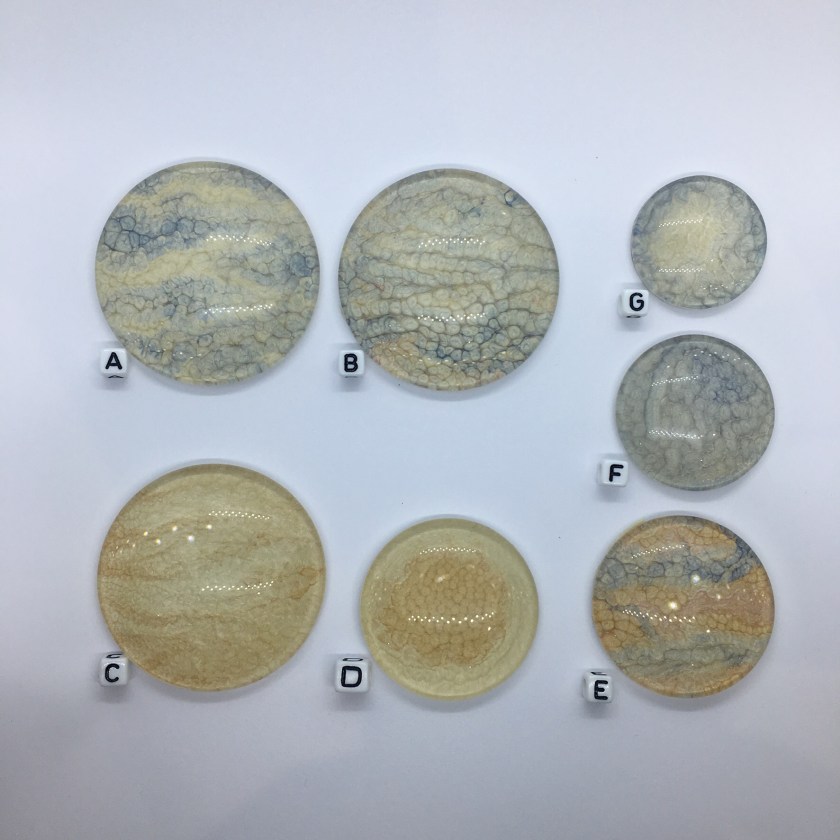

I’m somewhat ashamed to see how little I’ve posted over the last year or so, and I’m determined to change that, so be prepared for a flurry of posts as I catch up and tell you about what I’ve been up to.
First I need to tell you about my entry for this year’s Beadworker’s Guild Annual Challenge. The theme was ‘Jewels of the Nile’ – we were lucky enough to visit Egypt some years back, and Dr Indecisive Beader and I have always both been fascinated by all things Egyptological. I think my addiction stemmed initially from a desire to be Hercule Poirot in Agatha Christie’s ‘Death on the Nile’ (one of my favourite authors), and my more recent discovery of Elizabeth Peter’s ‘Amelia Peabody’ series has maintained my fascination long after the trip, so having said I’d have a year off after my win last year with Great Dixter, I immediately changed my mind as that theme was too ‘me’ to resist.
As usual this piece went through many aborted starts, abandoned designs and lots of iterations, many of which will reappear as new pieces over the next few months. In the end I focused on using my own cabs (poured specifically for this piece), lots of different bead embroidery and beadweaving techniques (including goldwork and three different beaded ropes) and a very wide assortment of new and vintage beads to make a classic, component based collar. I was really happy with the finished result – it’s quite eyecatching!
So here it is – Ra, Roth and Khepri (Sun, Moon & Scarab)

The wide collar section shows the day – Ra as the hot noon sun, with Khepri the scarab pushing the warm, coral setting sun and the cool, jade rising sun, connected by blue sky.
The strung blue sky continues into the counterweighting night section, with added ropes of golden stars supporting a deep hung pendant, showing the full and crescent moons of Roth on a goldwork barque.

Either Ra or Roth can be worn at the front, to suit your outfit (Roth looks amazing hanging above a backless dress).

Materials – custom handpainted cabochons (by me); Swarovski, Preciosa & vintage crystals; vintage cup chain; Miyuki beads; Czech shaped beads; felt, ultrasuede; goldwork purls, leather, handmade gold hook clasps.
Techniques – bead embroidery, goldwork embroidery, peyote, netting, stringing, CRAW, DCRAW, DRAW.
Sadly no prize for me this year (but I’ve brought home a prize for the last two years, and hadn’t even entered prior to that so I really can’t complain) – you can see all of the amazing entries on the guild site here if you’re interested. But I have a lovely piece, have worked out how to include goldwork techniques in bead embroidery, and have lots and lots of leftover components to make even more loveliness, including this necklace which is nearly done, so I’m going to count it as a personal win at least!